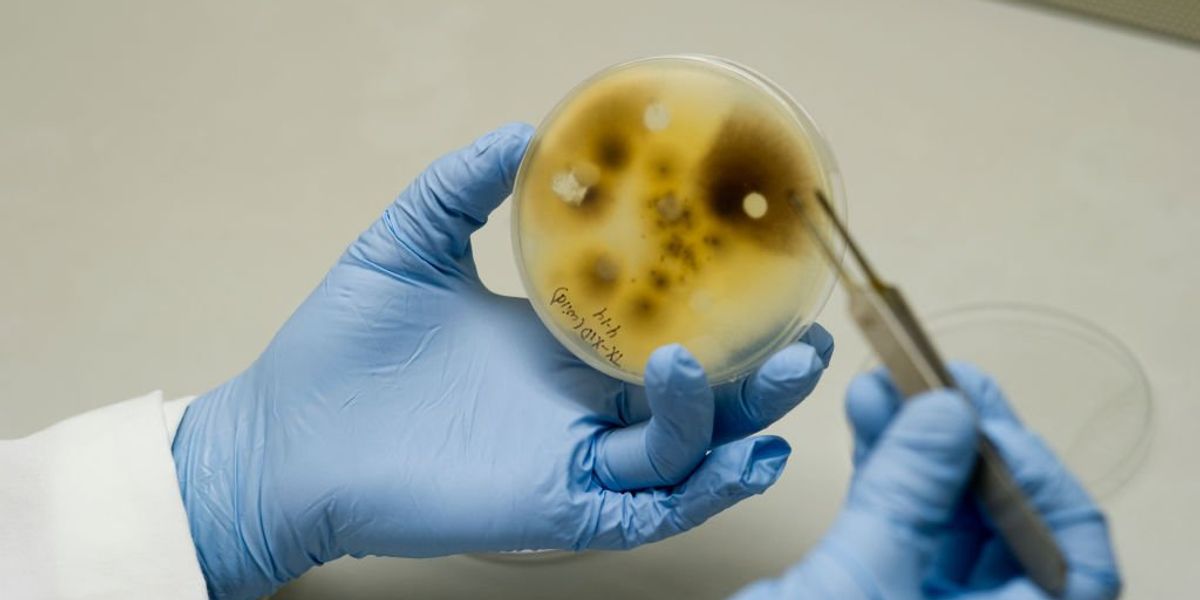
University of Michigan faces criticism over claims of Chinese scholars smuggling biological weapons.

Federal Investigations Into University of Michigan
The University of Michigan finds itself under federal scrutiny amidst a series of alarming potential national security threats.
In June, two Chinese researchers associated with the university faced accusations of trying to smuggle a harmful biological agent to the U.S. One of the suspects claimed that he intended to use the fungus Fusarium graminearum for research purposes at the university.
“Being a recipient of federal research funding, UM has both a moral and legal duty to maintain transparency regarding its foreign partnerships,” remarked an unnamed source.
Interim U.S. attorney Jerome Gorgon characterized the pathogen in question as “a potential agroterrorism weapon.”
Shortly after, another Chinese academic with connections to the university was arrested for attempting to send biological materials related to specific insects from Wuhan to Michigan.
This arrest seemingly triggered the Trump administration’s Department of Education to initiate an investigation into the university for possible violations of federal disclosure laws.
A letter sent Tuesday revealed that UM’s interim president, Domenico Grasso, asserted that the university had been transparent about its contracts related to Chinese research, though they were labeled “incomplete, inaccurate, or premature.” Since January 2021, the university has allegedly disclosed $375 million, including about $86 million that may have been improperly reported.
The letter also stated the university had sometimes misidentified the nature of certain counterparties as “non-governmental” in several of its disclosure reports.
Paul Moore, an investigative advisor linked to the Department of Education, mentioned that despite the University of Michigan’s past underestimations regarding foreign influence, recent revelations suggest that UM’s laboratories remain at risk of compromise.
“It’s disheartening that millions in foreign funding disclosed by UM may directly connect to entities tied to foreign governments, yet some funders were incorrectly classified as ‘non-governmental,'” he emphasized. “We are committed to investigating this further to clarify the true extent of foreign funding and its implications on campus.”
Colleen Mastony, UM’s Vice President of Public Relations, stated that the university is dedicated to advancing knowledge and solving pressing issues, and she asserted their commitment to comply with legal standards while condemning any actions that could threaten national security or undermine the university’s mission.